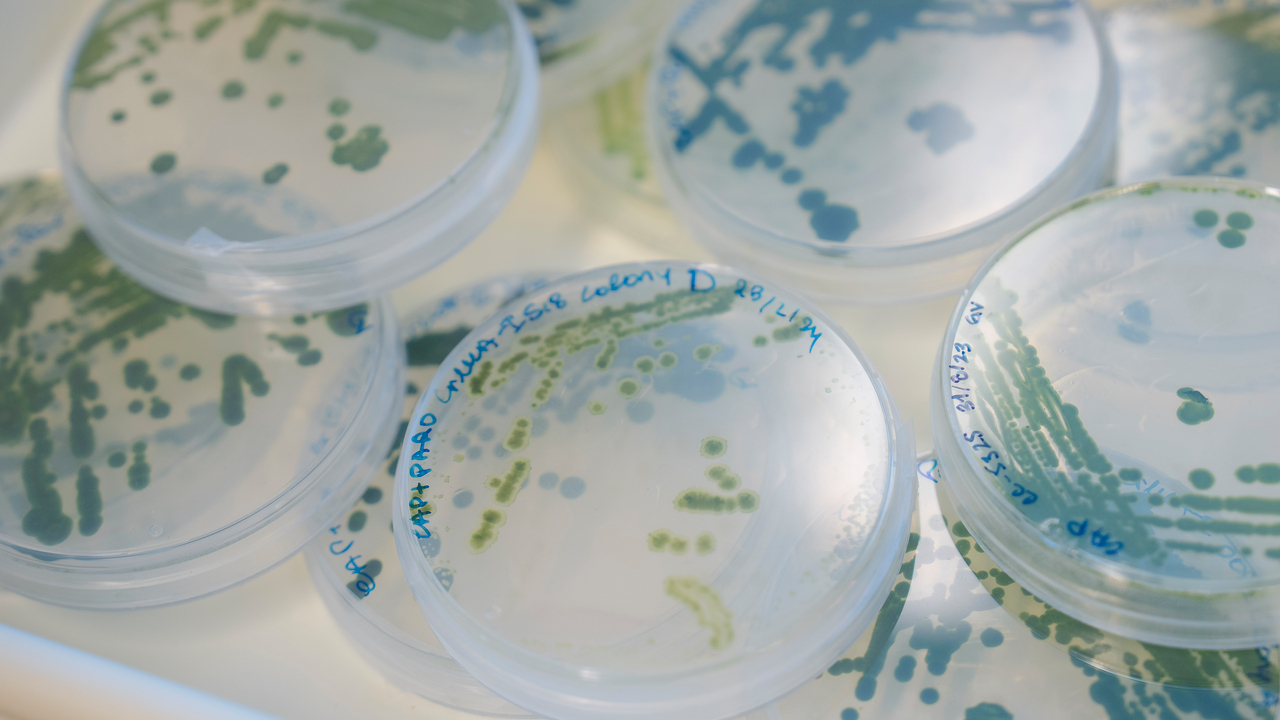
Christiane Funk

Expertlista: Life science, livsvetenskap
Bild: Mattias Pettersson
Du surfar just nu på en begränsad version av umu.se. Vad innebär det här?
Bild: Mattias Pettersson
Life science, eller livsvetenskap, handlar om studier av biologiskt liv och levande organismer. Det är ett brett område som innefattar allt från sjukdomar till hur vi fungerar och vårt samspel med naturen och alla dess komponenter.
Letar du efter experter inom CRISPR-Cas9 finner du det här.
Expertlista för klimatforskning finns här.
Listan uppdateras löpande.
Oliver Billker – Malaria, studerar malariaparasiten med mål är att avslöja dess biologi; kunskap som kan utnyttjas för nya läkemedel och vaccin mot malaria
Kontaktuppgifter till Oliver Billker, professor vid Insitutionen för molekylärbiologi.
Läs mer om Oliver Billkers forskning på hans forskarsida och i detta porträtt.
Barbara Sixt – Klamydia, samt hur celler själva kan bekämpa bakterier
Kontaktuppgifter till Barabara Sixt, forskare vid Insitutionen för molekylärbiologi.
Läs mer om Barbara Sixt forskning på hennes forskarsida samt i det här porträttreportaget.
Björn Schröder – Bakteriers och kosts påverkan på tarmen, tarmens bakterieflora
Kontaktuppgifter till Björn Schröder, forskare vid Insitutionen för molekylärbiologi.
Läs mer om Björn Schröders forskning på hans forskarsida eller lyssna på när han talar om Gofika – mums för microbiota? på Fika efter en forskare.
Jörgen Johansson – Antibiotikaresistens, multiresistenta bakterier och listeria
Kontaktuppgifter till Jörgen Johansson, professor vid Institutionen för molekylärbiologi.
Läs mer om Jörgen Johanssons forskning på hans forskarsida.
Fredrik Almqvist – Antibiotikaresistens, forskar kring nya behandlingar mot infektioner orsakade av multiresistenta bakterier
Kontaktuppgifter till Fredrik Almqvist, professor vid Kemiska insitutionen.
Läs mer om Fredrik Almqvists forskning på hans forskarsida eller om hans satsning för att bekämpa antibiotikaresistens.
Niklas Arnberg – Virussjukdomar, utbrott och pandemi, vaccin och läkemedel för virus
Kontaktuppgifter till Niklas Arnberg, professor vid Insitutionen för klinisk mikrobiologi.
Läs mer om Niklas Arnbergs forskning på hans forskarsida eller om lyssna på när han pratar om influensavirus på Fika efter en forskare.
Anna Överby Wernstedt – Forskar om hur TBE viruset infekterar celler och orsakar sjukdom, utvecklar strategier för att stoppa virusets spridning
Kontaktuppgifter till Anna Överby Wernstedt, professor vid Institutionen för klinisk mikrobiologi.
Läs mer om Anna Överby Wernstedts forskning på hennes forskarsida eller läs denna porträttintervju om henne och hennes forskning.
Tomas Gustafsson – Forskar om bakteriesjukdomen harpest samt utveckling av nya antibiotika mot gonorré
Kontaktuppgifter till Tomas Gustafsson, infektionsläkare samt forskare vid Institutionen för klinisk mikrobiologi.
Läs mer om Tomas Gustafssons forskning på hans forskarsida eller läs nyheten om riktad behandling vid harpest.
Teresa Frisan – Infektionsbiologi, studerar sambandet mellan långvariga bakteriella infektioner, bakterietoxinernas effekter och risken för tumörutveckling
Kontaktuppgifter till Teresa Frisan, professor vid Institutionen för molekylärbiologi.
Läs mer om Teresa Frisans forskning på hennes forskarsida. Teresa Frisan är även medansvarig för vårt kandidatprogram i Life Science, och kan svara på frågor om det.
Anne-Marie Fors Connolly – Använder omfattande befolkningsdata för att förebygga komplikationer efter infektioner, vilket bidrar till att förbättra folkhälsan och skydda sjukvårdspersonal under pandemier
Kontaktuppgifter till Anne-Marie Fors Connolly, universitetslektor och ST-Läkare vid Institutionen för klinisk mikrobiologi.
Läs mer om Anne-Marie Fors Connollys forskning på hennes forskarsida, eller pressmeddelandet om att infektionsläkare var som mest utsatta under pandemin. Intresserad av hjärt-kärlsjukdomar? när hon pratar om Virus – en risk för akuta hjärt-kärlhändelser?
Constantin Urban – Svampinfektioner och medfödd immunitet, studerar olika Candida stammar som kan orsaka allt från munsår till livshotande blodförgiftning. Forskar på nya behandlingar som kan blockerar svampen och hjälpa immunförsvaret att stå emot bättre.
Kontaktuppgifter till Constantin Urban, professor vid Institutionen för klinisk mikrobiologi.
Läs mer om Constantin Urbans forskning på hans forskarsida.
Ronnie Berntsson – Strukturbiolog, forskar om hur antibiotikaresistens sprids mellan bakterier
Kontaktuppgifter till Ronnie Berntsson, universitetslektor vid Institutionen för medicinsk kemi och biofysik.
Läs mer om Ronnie Berntssons forskning på hans forskarsida.
Henrik Sjödin – Ekologi kring infektionssjukdomar, global hälsa och epidemiologi. Tittar på miljö, ekosystem och sjukdomsspridning med hjälp av matematisk modellering och AI.
Kontaktuppgifter till Henrik Sjödin, forskare vid Institutionen för epidemiologi och global hälsa.
Läs mer om Henrik Sjödins forskning på hans forskarsida.
Anders Olofsson – Forskar om Alzheimers och Skelleftesjukan
Kontaktuppgifter till Anders Olofsson, universitetslektor vid Insitutionen för klinisk mikrobiologi.
Läs mer om Anders Olofssons forskning på hans forskarsida eller lyssna på när han talade om ifall det går att stoppa Alzheimers sjukdom under Fika efter en forskare.
Karin Forsberg – ALS, prövare i kliniska läkemedelsstudier med syfte att bromsa och förebygga ALS
Kontaktuppgifter till Karin Forsberg, universitetslektor och specialutbildad läkare vid Institutionen för klinisk vetenskap.
Läs mer om Umeå:s ALS forskning eller läs pressmeddelandet om genombrottsmedicinen för ALS som Forsberg var med att ta fram.
Fredrik Almqvist – Utvecklar substanser som hämmar amyloidbildning kopplat till Alzheimers, Parkinsons m.m, vilket kan leda till nya behandlingar
Kontaktuppgifter till Fredrik Almqvist, professor vid Kemiska insitutionen.
Läs mer om Fredrik Almqvists forskning på hans forskarsida.
Daniel Öhlund – Bukspottkörtelcancer, forskar kring att förstå och hitta hitta nya sätt att behandla/bromsa behandla sjukdomen
Kontaktuppgifter till Daniel Öhlund, birt. universitetslektor och specialistutbildad läkare vid Institutionen för diagnostik och intervention.
Läs mer om Daniel Öhlunds forskning på hans forskarsida eller läs porträttintervjun om honom.
Erik Chorell – Utvecklar innovativa läkemedelsstrategier med fokus på cancer, exempelvis genom design av molekyler som selektivt binder till specifika DNA-strukturer och reglerar sjukdomsrelaterade gener
Kontaktuppgifter till Erik Chorell, universitetslektor vid Kemiska institutionen.
Läs mer om Erik Chorells forskning på hans forskarsida eller läs pressmeddelandet om molekylen för cancerdiagnostik som hans forskarteam upptäckt.
Erik Chorell är även ansvarig för vårt kandidatprogram i Life Science, och kan svara på frågor om det.
Jenny Persson – Forskar inom användningen av artificiell intelligens, AI, för att tidigt upptäcka och effektivt behandla spridning av cancer
Kontaktuppgifter till Jenny Persson, professor vid Institutionen för molekylärbiologi.
Läs mer om Jenny Perssons forskning på hennes forskarsida eller läs reportaget om AI-teknologi för medicin.
Johan Henriksson – Använder modern genteknik för att omprogrammera kroppens egna T-celler, vilket kan leda till nya och effektiva behandlingar mot cancer. Utvecklar metoder för tidig cancerdiagnos.
Kontaktuppgifter till Johan Henriksson, forskare vid Institutionen för molekylärbiologi.
Läs mer om Johan Henrikssons forskning på hans forskarsida eller lyssna på när han pratar om kroppens hemligheter under Fika efter en forskare.
Elin Chorell – Undersöker kopplingar mellan fetma och typ 2-diabetes och hjärt-kärlsjukdomar. Använder avancerade kemiska analyser för förstå hälso- och sjukdomseffekter
Kontaktuppgifter till Elin Chorell, universitetslektor vid Institutionen för folkhälsa och klinisk medicin.
Läs mer om Elin Chorells forskning på hennes forskarsida eller läs porträttintervjun om henne och hennes diabetesforskning.
Johan Wikner – Expert inom marin mikrobiologi och miljövetenskap av betydelse för klimateffekter, biologisk mångfald, övergödning, syrebrist samt omsättning av organiska föreningar och näringsämnen i Östersjön och Ishavet i Arktis
Kontaktuppgifter till Johan Wikner, professor vid Insitutionen för ekologi, miljö och geovetenskap.
Läs mer om Johan Wikners forskning på hans forskarsida, eller läs om forskningsresan med isbrytaren Oden, "Ett arktiskt äventyr".
Stefan Jansson – Forskar om hur växter fångar in solljus och använder i fotosyntesen samt om genetik och genomik i träd. Även kunnig inom GMO, CRISPR-Cas9, växtförädling.
Kontaktuppgifter till Stefan Jansson, professor vid Institutionen för fysiologisk botanik.
Läs mer om Stefan Janssons forskning på hans sida vid Umeå Plant Science Centre. Stefan Jansson figurerar ofta i media, bland annat kring GMO, CRISPR-Cas9, och ibland även julgranar.
Laura Bacete Cano – studera mekaniken i växtcellernas väggar för att förstå hur de känner av och reagerar på sin omgivning; forskning bidrar till att förstå växters motståndskraft och kan inspirera till nya sätt att stärka grödor mot klimatförändringar.
Kontaktuppgifter till Laura Bacete Cano, Biträdande universitetslektor vid Institutionen för fysiologisk botanik.
Läs mer om Laura Bacete Canos forskning på hennes forskarsida vid Umeå Plant Science Centre.
Catherine Bellini – Expert inom växtcellbiologi, -molekylärbiologi och -utvecklingsbiologi som undersöker de cellulära mekanismerna bakom vegetativ förökning och hur ärftliga egenskaperna förs vidare till avkomman.
Kontaktuppgifter till Catherine Bellini, Professor vid Institutionen för fysiologisk botanik.
Läs mer om Catherine Bellinis forskning på hennes forskarsida vid Umeå Plant Science Centre.
Maria E. Eriksson – Forskar på växternas inre klocka och hur den reglerar tillväxt och årstidsbundna processer som t ex knoppvila och -sprickning hos perenner.
Kontaktuppgifter till Maria E. Eriksson, Universitetslektor vid Institutionen för fysiologisk botanik.
Läs mer om Maria E. Erikssons forskning på hennes forskarsida vid Umeå Plant Science Centre.
Verena Kohler – Åldrande på cellnivå
Kontaktuppgifter till Verena Kohler, biträdande universitetslektor vid Institutionen för molekylärbiologi.
Läs mer om Verena Kohlers forskning på hennes forskningsida.
Christiane Funk – Expert kring användning av microalger och biomaterial för återvinning och tillverkning av material, såsom bioplast.
Kontaktuppgifter till Christiane Funk, professor vid Kemiska institutionen.
Läs mer om Christiane Funks forskning på hennes forskarsida, eller ta del av hennes forskning kring att skapa nedbrytbar plast av alger.
Mattias Alenius – Forskar på smak, matpreferens och hur våra tarmar kan påverka smakupplevelse och i sin tur vad vi äter och suktar efter
Kontaktuppgifter till Mattias Alenius, professor vid Institutionen för molekylärbiologi.
Läs mer om Mattias Alenius forskning på hans forskarsida, eller läs om hur vi kopplar samman dofter med julen, eller hur våra tarmar påverkar att julmusten smakar sött.

Upptäck mer om life science vid Umeå universitet – studier av biologiskt liv och levande organismer.